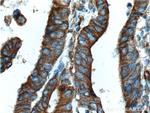
Occludin Antibody in Immunohistochemistry (Paraffin) (IHC (P))
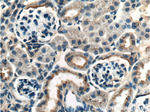
Occludin Antibody in Immunohistochemistry (Paraffin) (IHC (P))

Search
Proteintech
Occludin Monoclonal Antibody (1D3C4)
{{$productOrderCtrl.translations['antibody.pdp.commerceCard.promotion.promotions']}}
{{$productOrderCtrl.translations['antibody.pdp.commerceCard.promotion.viewpromo']}}
{{$productOrderCtrl.translations['antibody.pdp.commerceCard.promotion.promocode']}}: {{promo.promoCode}} {{promo.promoTitle}} {{promo.promoDescription}}. {{$productOrderCtrl.translations['antibody.pdp.commerceCard.promotion.learnmore']}}
产品信息
66378-1-IG
种属反应
宿主/亚型
分类
类型
克隆号
抗原
偶联物
形式
浓度
规格
纯化类型
保存液
内含物
保存条件
运输条件
产品详细信息
Immunogen sequence: RKMDRYDKS NILWDKEHIY DEQPPNVEEW VKNVSAGTQD VPSPPSDYVE RVDSPMAYSS NGKVNDKRFY PESSYKSTPV PEVVQELPLT SPVDDFRQPR YSSGGNFETP SKRAPAKGRA GRSKRTEQDH YETDYTTGGE SCDELEEDWI REYPPITSDQ QRQLYKRNFD TGLQEYKSLQ SELDEINKEL SRLDKELDDY REESEEYMAA ADEYNRLKQV KGSADYKSKK NHCKQLKSKL SHIKKMVGDY DRQKT (269-522 aa encoded by BC029886)
靶标信息
Occludin is a 65 kDa protein that can exist in a variety of phosphorylated forms, ranging up to approximately 82 kDa. Occludin is thought to be involved in regulating both the localization and the function of occludin. Polyunsaturated fatty acids are known to up-regulate occludin expression, increasing the transendothelial cell resistance and reducing the cellular permeability to large molecules. The level of occludin varies greatly depending on tissue; in brain tissue, occludin is highly and continuously expressed at cell-cell contact sites, whereas non-neural tissues show lower expression and discontinuous distribution. Overall structural features of the occludin protein are highly conserved in all the species examined. Under-expression of tight junction proteins, including occludin, is a key molecular abnormality responsible for the increased permeability of tumor endothelial tight junctions, which contributes to brain tumor edemas.
仅用于科研。不用于诊断过程。未经明确授权不得转售。
生物信息学
蛋白别名: Occludin; phosphatase 1, regulatory subunit 115; tight junction protein; unnamed protein product
基因别名: AI503564; BLCPMG; Ocl; OCLN; PPP1R115; PTORCH1
UniProt ID: (Human) Q16625, (Mouse) Q61146, (Rat) Q6P6T5
Entrez Gene ID: (Pig) 397236, (Human) 100506658, (Mouse) 18260, (Rat) 83497